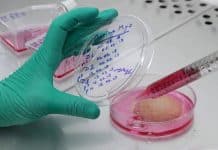

Salué par la critique dans son pays, ce documentaire américain remarquablement argumenté a été refusé par quasiment tous les festivals et les salles d’art et essai en France. Son tort ? Il dit du bien des OGM.
Sorti aux États-Unis en 2017, Food Evolution arrive en France en février 2019, à l’initiative d’un petit distributeur, 2iFilms/Infini Challenges. Signé du réalisateur Scott Hamilton Kennedy, le film présente les OGM le plus honnêtement possible, en parlant de leurs réussites, puisqu’il y en a[tooltips content= »Les cultures de papaye d’Hawaii ont été sauvés d’un virus par un OGM à la fin des années 1990. Des millions de consommateurs en mangent depuis plus de vingt ans. »](1)[/tooltips]. Il a été financé par un organisme international à but non lucratif, l’Institut of Food Technologists, qui regroupe 17 000 professionnels des technologies du vivant. Aux États-Unis, les critiques ont été excellentes. « Un ton mesuré, respectueux des opposants, mais insistant sur les données », écrivait le New York Times le 22 juin 2017.

En France, Food Evolution n’a pas été critiqué. Il a été écarté des écrans, occulté, blacklisté. « Il n’y a pas eu de complot et c’est ce qui rend l’affaire inquiétante », pointe Gil Kressmann, membre de l’Académie d’agriculture et porte-parole de l’Association française des biotechnologies du vivant (AFBV). Dès l’avant-première, organisée à l’école AgroParisTech en novembre 2018, le ton est donné. La salle est pleine, les débats sont vifs et la direction de l’école est sur ses gardes. Elle craint une intrusion des militants anti-OGM… Fin janvier 2019, coup dur : le film se voit refuser l’étiquette « Art et essai », indispensable pour être diffusé dans les salles labélisées. Les 15 experts du comité de sélection ont voté. Neuf voix contre, six votes blancs. Le distributeur demande un réexamen. Onze voix contre, zéro pour ! En février 2019, Télérama assassine le film en trois lignes, sans relever une seule inexactitude, sans l’analyser sur le fond (ce que l’hebdomadaire culturel serait bien en peine de faire). Les festivals le refusent, les uns après les autres. « Les associations comme Générations futures ou Nous voulons des coquelicots, qui sont hostiles par principe aux OGM, passent pour des centres d’expertise dans le milieu du cinéma », déplore Gil Kressmann.

En désespoir de cause, Eddy Agnassia, directeur de 2iFilms/Infini Challenges, écrit l’histoire de cette censure à bas bruit. Son texte, sobre et documenté, commence à circuler début 2020 et parvient à Jean-Baptiste Moreau, député LREM de la Creuse et agriculteur, qui organise une projection à l’Assemblée nationale, le 18 février. « Grâce à lui, une fenêtre va peut-être s’ouvrir pour une diffusion à la télévision, espère Eddy Agnassia. Je n’avais aucun a priori sur l’agriculture et les biotechnologies. J’ai découvert que le documentaire était devenu l’arme de propagande numéro un des militants. Ils adoptent une posture de dénonciation, façon Michael Moore, avec vingt-cinq ans de retard, ce qui permet d’évacuer le contradictoire, les nuances et l’objectivité. » Le tout sous les applaudissements. Demain, documentaire agresto-poétique de Mélanie Laurent et Cyril Dion sorti en 2015, a touché des aides publiques et a été projeté à la COP 21, malgré ses approximations[tooltips content= »Voire ses mensonges. « On plante des OGM qui rendent les animaux et les gens malades », assène le film, sans l’ombre d’une preuve. »](2)[/tooltips]. Aucune importance, constate Eddy Agnassia, car le but final est de formater les comportements : « Food Evolution ne va pas dans le sens de l’éducation des consommateurs, voilà ce que m’ont dit des organisateurs de festival, comme si un film sur l’agriculture devait forcément faire la promotion du bio et de la décroissance. J’attends toujours une objection sur le fond. » Y en a-t-il seulement ? Le 3 mars 2020, la projection de Food Evolution, lors de l’assemblée générale de l’AFBV, a été perturbée par des militants anti-OGM. Leur tract se terminait par cette phrase : « Nous soutenons l’agriculture paysanne et biologique : Martine à la ferme, c’est possible. »